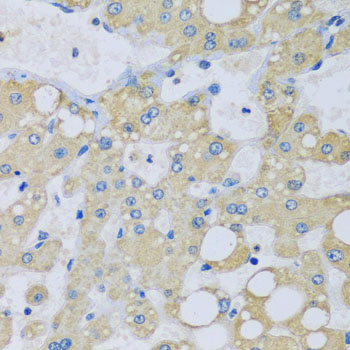

NDUFA7 Antibody (clone OTI2C3)
LS-C172891
ApplicationsFlow Cytometry, Western Blot, ImmunoHistoChemistry, ImmunoHistoChemistry Paraffin
Product group Antibodies
TargetNDUFA7
Overview
- SupplierLifeSpan BioSciences
- Product NameNDUFA7 Antibody (clone OTI2C3)
- Delivery Days Customer23
- ApplicationsFlow Cytometry, Western Blot, ImmunoHistoChemistry, ImmunoHistoChemistry Paraffin
- Applications SupplierFlo (1:100), IHC, IHC-P (1:150), WB (1:2000)
- CertificationResearch Use Only
- ClonalityMonoclonal
- Clone IDOTI2C3
- Concentration0.9 mg/ml
- ConjugateUnconjugated
- Estimated Purity...
- Gene ID4701
- Target nameNDUFA7
- Target descriptionNADH:ubiquinone oxidoreductase subunit A7
- Target synonymsB14.5a; CI-B14.5a; complex I B14.5a subunit; NADH dehydrogenase (ubiquinone) 1 alpha subcomplex, 7, 14.5kDa; NADH dehydrogenase [ubiquinone] 1 alpha subcomplex subunit 7; NADH-ubiquinone oxidoreductase subunit B14.5a
- HostMouse
- IsotypeIgG1
- Storage Instruction-20°C
- UNSPSC12352203